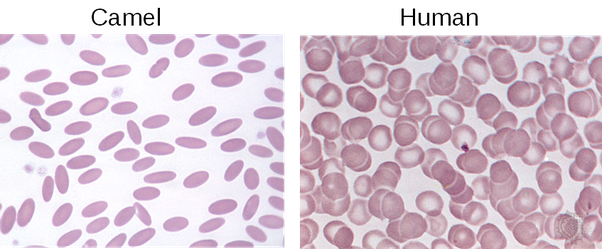

نقد صوفی نه همه صافی بیغش باشد
عرفان خسروی | منتشرشده در کانال پالئوگرام: t.me/paleogram/495
۱-کسی که چنین چیزی نوشته، بنابهدلائلی که خواهم گفت، مشغول مغلطه است و پیشفرضهای خودش را دارد و مسئله را هم حلشده فرض کرده. بنابراین نباید به فکر جواب دادن به چنین کسی باشیم. تنها جواب مفید برای کسانی خواهد بود که چشم و گوش خود را نبستهاند و ممکن است فریب این نوشته پرخطا را بخورند.

۲- پرندگان نه تنها از خزندگان تکاملیافتند، بلکه زیرگروه خزندگان هستند (برای اطلاعات بیشتر این مقاله را ببینید: خسروی، عرفان؛ «آیا پرندگان خزندهاند؟»، رشد آموزش زیستشناسی، زمستان ۱۳۹۲: t.me/paleogram/344). نخستین خطای فکری مغلطهآمیز همینجا آشکار میشود. منتقد باور دارد و میکوشد به ما هم چنین وانمود کند که خزندگان صفاتی ذاتی و بیتغییر دارند از قبیل خونسرد بودن؛ پرندگان نیز صفات ذاتی متفاوتی از قبیل خونگرم بودن دارند. منتقد سعی دارد خزندگان و پرندگان را در دو دایره مجزا با تفکیک ذاتی بنشاند و نشان دهد قرابت میان اینها بعید است. اما واقعیت این است که نظریه تکامل داروین اول از همه نافی ذاتگرایی است و اصالتی برای مفهوم غیرعینی ذات این گروه و آن گروه قائل نیست. داروین گرچه هرگز وارد عرصه ردهبندی نشد، اما در یادداشتهایش، اشاره میکند که تنها معیار راستین و عینی برای ردهبندی را «خویشاوندی» و همخونی میداند. مدتها پس از داروین، بر اساس تمامی شواهد کنونی که در دست داریم (نه فقط تعدادی سنگواره) میدانیم خویشاوندی پرندگان و تمساحها نزدیکتر است تا خویشاوندی بقیه خزندگان زنده کنونی با تمساحها؛ پس نه تنها پرندگان هم جزء خزندگان هستند، بلکه تصور و تصویر ذهنی پیشینیان ما از خزنده به عنوان جانوری که ذاتا میخزد و خونسرد است، اشتباه از آب درمیآید.

۳- پرندگان تنها خزندگان خونگرم نیستند. تگوهای ابلق آرژانتینی (Salvator merianae) یکی از معدود سوسمارهای امروزیاند که قادر به تنظیم و بالابردن دمای بدن با گرمای درونی خود هستند. دمای بدن بسیاری از گروههای منقرضشده خزندگان (طبق شواهد انکارناپذیر) ثابت و بالاتر از دمای محیط بوده است. این گروهها حتی خویشاوند نزدیک یکدیگر هم نبودهاند. بررسی میزان ایزوتوپهای اکسیژن در استخوانهای دو گروه از خزندگان آبزی (ایکتیوسورها و پلسیوسورها) نشان میدهد آنها خونگرم بودند. به جز این دو گروه، تروسورها (خزندگان پروازگر اما نامرتبط به نسل پرندگان) و احتمالا همه دایناسورها نیز خونگرم بودند. بدن تروسورها از ساختاری شبیه مو (بیارتباط تکاملی با موی پستانداران) پوشیده بود و بدن دایناسورهای گوشتخوار و بسیاری از دایناسورهای گیاهخوار از پر و کرکپر. البته پژوهشهای مبتنی بر ایزوتوپهای اکسیژن نیز خونگرم بودن دایناسورها را تایید میکنند.

۴-خونسرد بودن، «خصلت ژنتیک» نیست که «گمشود»، بلکه فقدان نسبی یک خصلت (توانایی تولید گرما و تنظیم دما) است. همانطور که فقدان چرخ یا فقدان فرستنده مایکروویو برای جانداران «خصلت» نیستند. تعبیر «خصلت ژنتیک» برای فقدان یک صفت، نشانه دیگری از رسوخ افکار ذاتگرایانه در ذهن و زبان منتقدی است که میکوشد با این مغلطه ذهن مخاطب را درگیر و منحرف کند. تمام نظریه داروین بر این باور بناشده که هیچ خصلت ذاتی و تغییرناپذیری وجود ندارد و نه تنها هر موجود خونسردی ممکن است روزی تکامل یابد و خونگرم شود، حتی خونسرد شدم دوباره موجودات خونگرم نیز بعید نیست. تگو، سوسماری امروزی و خونگرم است. چند گونه ماهی استخوانی خونگرم (تن، نیزهماهی، ماهماهی) و ماهی غضروفی خونگرم (کوسههای خانواده Lamnidae)، حشرات خونگرم (برخی بیدها و برخی زنبورها) و حتی گیاهان خونگرم (کلممرداب یا Symplocarpus foetidus، شیپور لاشهاسب یا Helicodiceros muscivorus، سیبزمینی فیلی یا Amorphophallus konjac، فیلودندرون برگانجیری یا Philodendron bipinnatifidum و از همه مشهورتر گل لاشه یا Amorphophallus titanum، همگی از خانواده Araceae) نمونههای خوبی از موجوداتی هستند که از نسل نیاکان خونسرد تکامل یافتهاند. متقابلا دمای بدن و سوختوساز برخی پستانداران از جمله برخی خفاشها در زمان استراحت و فعالیت تفاوت فاحش دارد یا در دورههایی (خواب زمستانی) کاهش مییابد. حتی نرخ رشد و سوختوساز در برخی پستانداران (به ویژه اغلب زوجسمان و برخی گوشتخواران) در فصل زمستان (حتی در گونههای ساکن مناطق معتدل و گرمسیر) به قدری کاهش مییابد که حلقههای توقف رشد در استخوانهای آنها به جای میگذارد.
۵- گویچههای سرخ شتر مثل بقیه پستانداران بیهسته است. ویژگی متمایز گویچههای سرخ شتر، بیضویبودن آنهاست. این صفت متمایز برای افزایش مقاومت این یاختهها نسبت به تغییرات شدید اسموتیک خون این جانور بیابانزی است؛ خون شتر پس از مدتها تشنگی، با نوشیدن حجم زیادی آب، ناگهان به شدت رقیق میشود. این تنشهای اسموتیک برای بقیه پستانداران مرگبار است ولی به لطف ریختشناسی گویچههای سرخ خون شتر، آسیبی به این جانور وارد نمیکند.

۶- تنبلها میمون نیستند. سوخت و ساز بسیار پایینی دارند و میتوان گفت تقریبا خونسرد هستند، گرچه گویچههای سرخ و ویژگیهای دیگرشان نشانه نیاکان خونگرم آنها در گذشته نزدیک است.
۷- جالبترین نکته در مدعیات منتقدان نظریه تکامل اینجاست که نه تنها ذاتگرا هستند و میکوشند همه خزندگان را شبیه یکدیگر قلمداد کنند یا همه پرندگان و پستانداران را مثل هم در دسته خیالی «حیوانات خونگرم» بچینند و خلاصه نافی تفاوت میان گونههای مختلف هستند، بلکه از سوی دیگر وقتی به موجودی متفاوت میرسند که تفاوتهایی غیرقابلانکار با خویشاوندان نزدیکش دارد، ناگهان «حکمتگرا» میشوند و مثل اینجا تفاوتهای تنبل را به عنوان شاهدی نقیض نظریه تکامل به ما نشان میدهند.